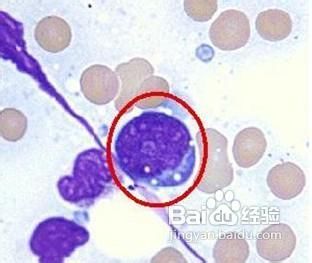
再生障碍性贫血的诱发原因

再生障碍性贫血的诱发原因
1、造血干细胞减低或异常:大量实验研究证明造血干细胞缺乏或有缺陷是再生障碍性贫血的主要发病机理。至少有50%以上的再障是由于造血干细胞缺乏引起的。通常将骨髓造血干细胞比做“种子”,它可以增殖、分化、发育成为红细胞、粒细胞和血小板。若造血干细胞缺乏,可使全血细胞减少。

2、造血微环境异常:骨髓中造血组织减少,红骨髓总容量减少,以脂肪组织代替,使全血细胞减少。
另外,若造血微环境发生改变,也不利于血细胞的正常生长发育。
3、免疫功能异常:临床上为再障病人作骨髓移植时,多数病人可因输同基因骨髓才能恢复造血功能。这说明再生障碍性贫血的病人免疫功能异常。
声明:本网站引用、摘录或转载内容仅供网站访问者交流或参考,不代表本站立场,如存在版权或非法内容,请联系站长删除,联系邮箱:site.kefu@qq.com。
阅读量:114
阅读量:167
阅读量:157
阅读量:92
阅读量:30